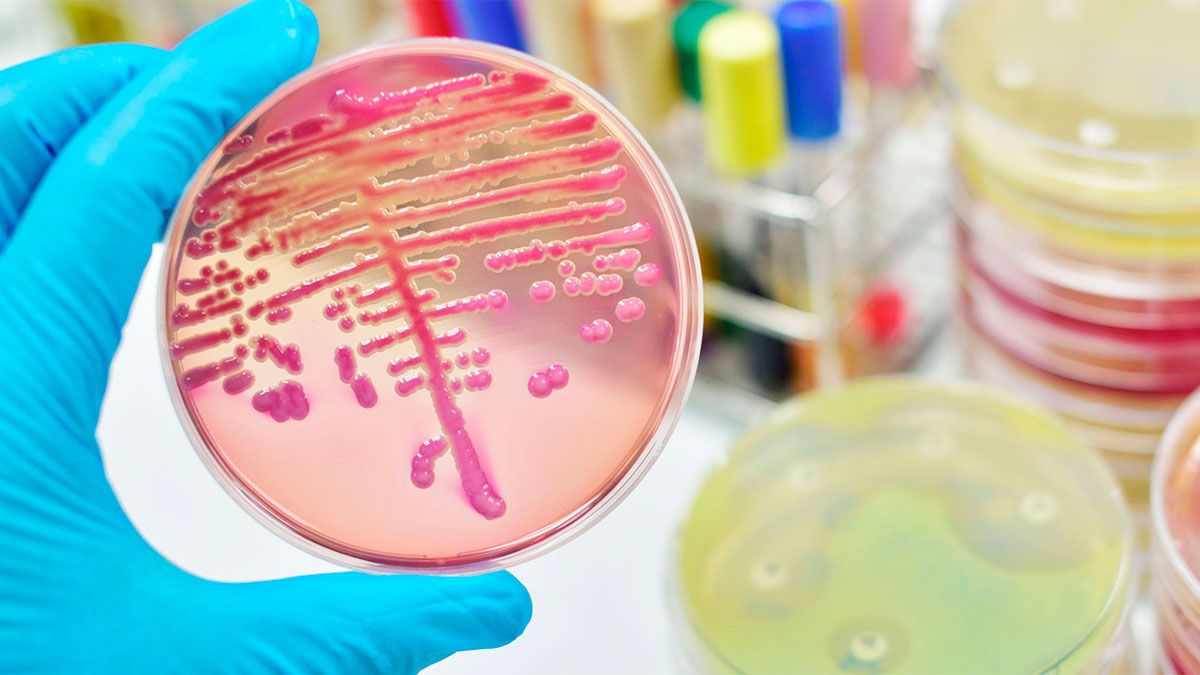

Detectaron una "superbacteria" resistente a 30 antibióticos en pacientes de Argentina
Se trata de cepas de la bacteria Klebsiella pneumoniae. El Instituto ANLIS/Malbrán emitió un alerta.
Se llama Klebsiella pneumoniae y es una bacteria que fue descripta en 1882 después de ser aislada de los pulmones de pacientes en Europa que habían muerto por neumonía. Suele colonizar la boca, la nariz y el tracto gastrointestinal en los seres humanos, pero también afecta a otras especies.
En la Argentina, por primera vez se detectaron cepas de la bacteria Klebsiella que eran resistentes a los 30 antibióticos disponibles. Afectaron a pacientes hospitalizados. Incluso esas cepas fueron capaces de resistir a los carbapenems, que son un grupo de medicamentos que se reservan para tratar infecciones que no son sensibles a otros antibióticos.
Klebsiella
Klebsiella
Ante el riesgo que implican las superbacterias para la salud pública, el Servicio Antimicrobianos del INEI-ANLIS “Dr. Carlos G. Malbrán”, que depende del Ministerio de Salud de la Nación, emitió un alerta.
Ese centro de referencia nacional informó a los profesionales de la salud, los hospitales y a la comunidad en general que se ha “confirmado la emergencia y diseminación de Enterobacterales productores de carbapenemasas con resistencia a todos los antimicrobianos disponibles en Argentina”.
El fenómeno se conoce técnicamente como “panresistencia”. Esto significa que las cepas de Klebsiella eran resistentes a todos los antibióticos disponibles en el país.
Generalmente, las infecciones por Klebsiella suelen producirse en pacientes enfermos que reciben tratamiento para otras afecciones en hospitales. Las personas sanas no suelen contraer infecciones por esa bacteria.
Según el alerta emitido, se hicieron 3 aislamientos de Klebsiella en pacientes de una institución privada de salud de la Ciudad de Buenos Aires. Fue a partir de muestras de orina de esos pacientes, quienes tenían entre 38 y 54 años.
El doctor Fernando Pasteran, investigador del ANLIS/Malbrán, explicó al portal de Infobae: “Es la primera vez que detectamos que una bacteria que afecta a pacientes hospitalizados en la Argentina resulta ser simultáneamente resistente a los 30 antibióticos disponibles, incluyendo los más nuevos”.
El científico aclaró que se trata de “un punto de inflexión importante para el problema de la resistencia antimicrobiana en la Argentina. Implica que ya es una realidad que el país tiene bacterias resistentes a todos los antibióticos”.
Como los antibióticos disponibles no podían controlar las infecciones que tenían los pacientes hospitalizados, se activó un protocolo de uso compasivo y se hizo una combinación de tres medicamentos, que hasta ese momento no se había probado. Ninguno de los medicamentos disponibles hubiera sido efectivo si se lo administraba solo. En cambio, la combinación funcionó favorablemente para los pacientes.
“Las cepas de bacterias que tenían los pacientes fueron sensibles a una combinación de tres antibióticos. Igualmente, no es una combinación que se pueda sostener en el tiempo porque la bacteria podría desarrollar resistencia a la triple terapia que recibieron los pacientes”, explicó Pasteran.
Los tres pacientes que figuran en el alerta del ANLIS/Malbrán se recuperaron por la triple combinación de medicamentos. “Después se detectaron otros 5 pacientes más. También sobrevivieron”, señaló el científico.

Ante el alerta sobre los antibióticos, expertos consideraron que hay muchas medidas para implementar y que toda la sociedad debería involucrarse. Cualquier persona podría ser afectada directa o indirectamente por el problema de la resistencia a los antibióticos, y no es sólo una cuestión de la comunidad médica.
Adrián Morales, vicepresidente de la Sociedad Argentina de Infectología, explicó: “Se encontraron pacientes con bacterias panresistentes. Este hallazgo es producto del sobreuso de los antibióticos que se ha realizado durante los últimos años”.
El alerta es -según Morales- un llamado de atención ambiental para toda la población. “Hay que reducir el uso de los antibióticos en los animales dentro de la ganadería, la pesca y otros rubros para controlar el problema de la resistencia a los antimicrobianos”, subrayó.
“Así como hay preocupación por el cambio climático, la comunidad general también debería prestarle más atención al uso de los antibióticos como una medida de cuidado por el planeta. Se debe evitar la automedicación. Se deben usar correctamente los medicamentos: solo cuando los indiquen los profesionales de la salud”, enfatizó Morales.
“En los hospitales, -recordó el especialista- se necesita que se refuercen los programas de control de infecciones para prevenir que los pacientes con bacterias resistentes transmitan a otras personas internadas o por fuera de la institución”. De acuerdo con el representante de SADI, “estamos en un momento de riesgo en que se puede volver a la era anterior a los antibióticos: una infección sin tratamiento puede tener una alta mortalidad”.
En tanto, para Inés Staneloni, co-fundadora de la asociación Investigación de la Resistencia Antimicrobiana (INVERA) y ex jefa del comité de control de infecciones del Hospital Italiano de Buenos Aires, “la identificación de bacterias resistentes a todos los antibióticos disponibles es una gran preocupación. Debería convocarnos a todos a la acción. Todos podemos accionar para frenar la resistencia a los antimicrobianos”.
 instituto malbran
instituto malbran
Hoy es importante que “los pacientes o sus familiares no presionen a los médicos para que indiquen antibióticos cuando no son necesarios. La mayoría de las infecciones son virales. Y los antibióticos no son útiles para combatirlas. Al usarlos cuando no corresponde, se generan bacterias más resistentes”, argumentó la doctora Staneloni.
Otra acción fundamental para la comunidad “es prevenir infecciones con buenas prácticas como las vacunas y la higiene de manos. Porque si hay menos infecciones, hay menos uso de antibióticos. Y para aquellos que están trabajando en ámbitos de la salud, tienen que sumarse a los programas de control de infecciones y de uso adecuado de antimicrobianos. Todos somos parte de algunos de esos programas. Esta realidad nos llama a todos ser parte de este cambio dentro y fuera de los hospitales”, dijo Staneloni.
Para contrarrestar al problema de la resistencia antimicrobiana, el doctor Pasteran comentó que se necesita de la disponibilidad en el país de los fármacos amoxicilina/ácido clavulánico endovenoso (por el momento solo están los que se administran por vía oral), el cefiderocol, la combinación de meropenem y vaborbactam, y el sulbactam-durlobactam.
También se necesita que la Argentina cuente con tecnología para evaluar las combinaciones de antibióticos más rápidamente, que permiten evaluar cuáles son los fármacos que pueden funcionar en pacientes con pan-resistencia.
Los expertos resaltaron que aún está en marcha la verdadera implementación de la ley para la prevención y el control de la resistencia a los antimicrobianos, que se sancionó el año pasado. A partir de la sanción de esa norma por el Congreso, Argentina se convirtió en el primer país de América del Sur que cuenta con una ley dedicada al problema de la RAM. Se hizo bajo el nuevo paradigma de “Una Salud”, que abarca la salud humana, animal y ambiental.
La ley fue sancionada por unanimidad y obliga a la venta bajo receta archivada de los antibióticos. Eso significa que quien prescriba un antimicrobiano (ya sea un antibiótico, un antiviral, un antifúngico o un antiparasitario) debe entregar al paciente la receta original y una copia o duplicado para que una de ellas quede archivada en la farmacia en la que será dispensado.
Además, se debe incorporar en la prescripción el diagnóstico por el cual se indica su uso, según explicó el año pasado la cartera de Salud nacional, a cargo de Carla Vizzotti.
Fuente: Infobae
LAS + LEÍDAS AHORA EN SANTIAGO DEL ESTERO
- 1. Una menor de 14 años terminó en el Regional tras ser abusada por su novio de 16
- 2. El chef Christian Petersen sufre una “Falla multiorgánica”, según el primer informe oficial
- 3. Uno en contramano: choque entre dos motos provocó heridas a cuatro personas
- 4. “Dejamos de ser aliados”: la sesión en diputados generó nueva tensión entre el PRO y LLA
- 5. Clima para este viernes 19 de diciembre en Santiago del Estero: caluroso y con probabilidad de tormentas aisladas